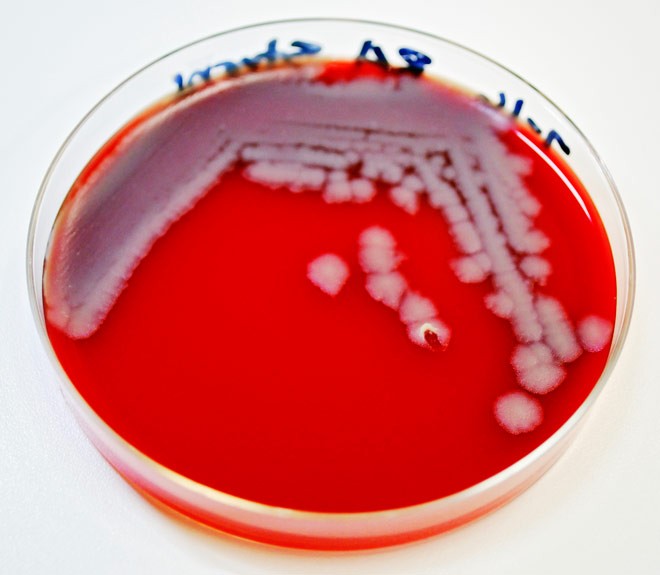

Tout juste une semaine après les attentats du 11 septembre 2001, débutait laffaire des lettres à lanthrax qui firent 5 morts et infectèrent 17 autres personnes. Lenquête du FBI qui suivit baptisée "Amerithrax" semble être la plus coûteuse et la plus longue que le Bureau ait jamais connue. Pourtant ses conclusions restent encore confuses. Si dans ce contexte les yeux se tournèrent de prime abord vers Al-Qaïda et lIrak en tant que coupables idéals, le FBI concluera son enquête sur la thèse du fou solitaire en la personne de Bruce Ivins, un chercheur de lInstitut de recherche médicale de larmée sur les maladies infectieuses (USAMRIID) qui selon le réalisateur Bob Coen (voir liens), connaissait bien un autre suicidé notoire, le professeur britannique David Kelly. Malgré de nombreuses critiques, dont celle du sénateur Patrick Leahy qui fut un des destinataires des lettres à lanthrax, le FBI déclara le 6 août 2008 que Bruce Ivins était le seul coupable, 10 jours après que celui-ci se fut donné la mort, et classa pour de bon le dossier le 19 février 2010.
Alors quun rapport psychiatrique, diffusé mardi 22 mars 2011, tente de fournir un mobile à Bruce Ivins en lien avec son enfance difficile, le magazine Wired propose de revenir plus en détail sur cette enquête du FBI qui continue de déranger. Nous vous présentons cet article en deux parties dont voici la première.
Anthrax revisité : Le FBI a-t-il coincé le mauvais gars ?
Par Noah Shachtman le 24 mars 2011 pour le magazine Wired davril 2011
Illustrations : Goñi Montes
Traduction : Jacques
 Finalement, lenquête était finie.
Finalement, lenquête était finie. Lénigme résolue. Le 18 août 2008 presque sept ans après,10000 interrogatoires et des millions de dollars pour développer une forme totalement nouvelle de biologie médico-légale quelques-uns des meilleurs limiers du FBI se réunirent dans une salle mal éclairée et remplie de drapeaux à leur quartier général à Washington DC. Ils étaient là pour présenter les preuves démontrant qui était responsable des attaques à lanthrax qui terrifièrent les Etats-Unis à lautomne 2001.
Les journalistes réunis à cette occasion furent informés que cette enquête avait été laffaire la plus coûteuse, et sans doute la plus difficile, de lhistoire du FBI. Mais les faits démontraient que le chercheur en biodéfense de lArmée de terre Bruce Ivins était responsable de la mort de cinq personnes et de la maladie de 17 autres durant ces semaines inquiétantes qui suivirent le 11 septembre 2001. Cétait Ivins, ils en étaient maintenant certains, qui avait posté ces lettres contenant de lanthrax, exposant ainsi plus de 30000 personnes aux spores mortelles.
Le FBI avait résolu le mystère, dirent les responsables, en partie grâce aux microbiologistes assis à une table en U dans la salle. Parmi eux, Paul Keim, qui fut le premier à identifier la souche danthrax utilisée dans les attaques, et la généticienne Claire Fraser-Liggett, qui dirigea léquipe de séquençage de lADN de lanthrax, permettant de remonter jusquà son double génétique : un flacon danthrax super-concentré et ultra-pur détenu par Ivins. Plusieurs de chercheurs réunis autour de la table avaient été des collègues, et même des amis, dIvins. Maintenant, ils contribuaient à le dépeindre comme un monstre.
Les responsables et les scientifiques formaient un groupe imposant. Cétait nécessaire. Ivins sétait suicidé trois semaines auparavant. Il ny aurait pas darrestation, pas de procès, pas de condamnation. En labsence dune cour de justice et dun verdict, tout ce que le FBI pouvait faire était de présenter ces trouvailles et de déclarer laffaire close.
Aucune des personnes présentes nexprima le moindre doute concernant la culpabilité dIvins. Mais les choses ne sont pas toujours aussi évidentes quelles semblent lêtre lors dune présentation du FBI. Deux ans plus tard, assise dans son bureau dominant louest de la ville de Baltimore, Fraser-Liggett admet quelle a des doutes. « Il reste quelques lacunes » dit-elle, détournant le regard vers la fenêtre, gênée. A presque 2000 kilomètres de là, à Flagstaff, Arizona, Keim a ses propres préoccupations. « Je ne sais pas si Ivins a envoyé ces lettres » dit-il avec de lirritation et de la tristesse dans la voix. Même lagent Edward Montooth, qui a dirigé la chasse du FBI au tueur à lanthrax, dit que même sil reste convaincu quIvins a bien envoyé les lettres il est moins sûr sur beaucoup dautres points, de la motivation dIvins au moment où il a produit les spores mortelles. « Nous avons encore de la peine à fixer la chronologie, dit-il. Nous ne savons pas quand il a produit ou séché les spores. » En dautres termes, dix ans ont passé depuis que la plus mortelle attaque bioterroriste de lhistoire américaine a conduit à une chasse à lhomme qui a ruiné la réputation dun scientifique et poussé un autre au suicide, et certains problèmes lancinants demeurent. Des problèmes qui sempilent en une réalité dérangeante : malgré les déclarations du FBI, il nest pas certain que le gouvernement aurait pu poursuivre Ivins pour crime.
Cela a pris des semaines pour que quelquun se rende compte que les attaques avaient eu lieu. Lorsque Robert Stevens, un éditeur de la section photographie du tabloïd Sun, ressentit des frissons lors de vacances en Caroline du Nord le 29 septembre 2001, ni lui ni sa femme nont pris cela au sérieux. Elle est allée passer laprès-midi avec leur fille, lui est resté allongé. A ce moment-là, des milliers de spores remplissaient déjà ses poumons. Blottis dans les sacs respiratoires, les particules sont entrées lentement en contact avec les macrophages des cellules blanches présentes dans le sang qui ont transporté les bactéries vers les nuds lymphatiques de la cavité centrale dans sa poitrine (médiastin). Là, les germes se sont développés, se sont débarrassés de leur enveloppe et multipliés sans relâche. Les bactéries ont déversé deux types de toxine dans le système sanguin de Stevens. Le premier a causé une accumulation de liquide dans le médiastin, compressant son cur et ses poumons contre ses côtes, rendant sa respiration difficile. Le second a commencé à tuer les macrophages de Stevens, décimant ses défenses naturelles.
Deux jours plus tard, Stevens était fiévreux, essoufflé et apoplectique. Lui et sa femme se mirent en route pour rentrer chez eux en Floride ; Stevens dégoulinait sur son siège. A leur arrivée, sa femme laccompagna à lhôpital, dans un état délirant. Le 4 octobre, la contamination à lanthrax était confirmée. Le lendemain, il décédait.
Les médecins et les responsables de santé publique pensèrent quil sagissait dun cas anormal mais naturel, peut-être contracté par Stevens lors dune randonnée dans les forêts de Caroline. Lanthrax étant connu comme un agent potentiel de guerre bactériologique, le cas attira lattention au niveau national, mais sans générer de panique. « Cela semble être un cas isolé » dit le président George W. Bush à la nation le 9 octobre.
Trois jours plus tard, une lettre à lanthrax était trouvée dans les bureaux centraux de NBC News. Une semaine plus tard, le FBI récupérait une lettre identique dans les bureaux du New York Post. La lettre contenait le message suivant : « 11 septembre 2001 / Ceci esT la suiTe / Prenez de lA pénicAlline / MorT à lAmérique / MorT A Israël / Allah esT grand ».
A la mi-octobre, quatre personnes supplémentaires étaient contaminées à lanthrax et Leroy Richmond, un employé du centre de tri postal de Brentwood Road à Washington DC, essayait de convaincre ses collègues de se relaxer. Le personnel de tri ne risquait presque rien, pour autant que les mesures de précaution soient respectées, selon les dires du gouvernement, lus à haute voix par Richmond à ses collègues. Bacillus anthracis apparaîtra sous la forme dune poudre blanche que vous devrez garder éloignée de votre visage. Soyez prudents, mais continuez votre travail, dit Richmond tout en reniflant. Tout ira bien.
Quelques jours plus tard, Richmond arrivait à peine à traverser le rez de chaussée de la salle de tri, où passent le courrier du Sénat et de dizaines dagences gouvernementales. Ses épaules et sa poitrine lui faisaient mal, comme frappées à coup de bâton. « Mon dieu, pensa-t-il, cest peut-être mon dernier souffle ». Le 20 octobre, les docteurs de lhôpital Inova de Fairfax confirmaient quil était contaminé à lanthrax.
Richmond survécut, mais pas ses collègues Thomas Morris et Joseph Curseen.
La lettre qui les avait vraisemblablement infectés fut découverte dans le bureau de Tom Daschle, chef de la majorité au Sénat. La lettre portait un tampon de Trenton, New Jersey, et une adresse au dos écrite en majuscules : « 4e primaire, école de greendale ». Une équipe du FBI revêtue de scaphandres plaça la lettre et lenveloppe dans un container scellé, puis lachemina à une cinquantaine de kilomètres de là à Fort Detrick, au fameux Institut de recherche médicale sur les maladies infectieuses de larmée de terre US (USAMRIID), le principal centre de biodéfense militaire.
John Ezzell, un barbu chevauchant une Harley, dirige le Laboratoire de test des pathogène spéciaux à lInstitut. Il attendait les agents du FBI. Il passa la journée à analyser lemballage, puis lenvoya à Bruce Ivins, un des meilleurs connaisseurs de lanthrax de lInstitut. Ivins enfila ses mains revêtues de gants doublés dans le boîtier de biosécurité contenant léchantillon, sous le regard de ses collègues microbiologistes massés dans le couloir. Il ouvrit lemballage dune main. Lorsquil approcha son autre main, les granules dans lemballage se déplacèrent vers son gant, attirées par une faible charge électrostatique. Les microbiologistes haletèrent ; ils étaient habitués à travailler avec des spores humides, qui tombaient facilement vers le sol. Mais cet anthrax était sec et ionisé il resterait en suspension et se répandrait comme un gaz. Il était potentiellement mortel pour quiconque se trouvait à proximité. « Cétait incroyable, dit Ivins selon un collègue, je nai jamais rien vu de pareil. »
Ivins mesura la concentration de léchantillon : un milliard de spores par gramme trois ordres de grandeur plus concentré que tout ce que les chercheurs navaient jamais obtenu. « Ce ne sont pas des spores développées dans un garage, écrira plus tard Ivins dans un rapport ; des techniques de production professionnelle ont été utilisées. »
 S
Si quelquun à lInstitut connaissait quelque chose à propos de la production de spores, cétait bien Ivins. Après deux décennies passées à lInstitut, il avait maîtrisé léquilibre délicat de chimie, de chaleur et de temps nécessaire à la multiplication danthracis. Ivins fournissait en spores non seulement ses collègues de lInstitut, mais aussi la plupart des chercheurs mondiaux sur lanthrax.
En plus de son expertise sur lanthrax, Ivins était connu comme un personnage très singulier dans un institut plein de personnages singuliers. Il pouvait venir travailler en pantalons patte deph à carreaux et chemises à fleurs, de plusieurs tailles trop petites pour son gabarit de fil de fer. Cétait un jongleur, un mono-cycliste et un fana de météo. Aux Noëls de lInstitut, cest lui qui récitait les limericks grivois [sonnets populaires d'origine irlandaise, NdT.]. Au fitness, il sentraînait en chaussettes noires et en grosses chaussures.
Fils du pharmacien local, minçolet, amateur de science, Ivins grandit dans la petite ville de Lebanon, Ohio. Il étudia à luniversité de Cincinnati, où il rencontra sa femme, Diane, et y obtint son bachelor, son master et son doctorat en microbiologie. Après un post-doctorat à luniversité de Caroline du Nord, le couple sinstalla dans le Maryland, où est situé lInstitut dans lequel Ivins fut engagé en 1981. Deux ans auparavant, une dissémination danthrax dans une installation militaire secrète en Sibérie tuant au moins 66 personnes démontra que les Soviétiques avaient raffiné lanthrax en une arme biologique. Ivins fut engagé pour initier la recherche dun nouveau vaccin, plus efficace.
Ivins était un pilier des activités sociales et sportives de lInstitut. Diane se tenait à distance, bien quils eurent vécu à quelques pâtés de la base avec leurs enfants adoptés, Andy et Amanda. (La famille Ivins a refusé nos demandes répétées dinterview.). Ivins participait donc seul aux tournois de volley-ball pas pour jouer, mais pour samuser et se moquer des arbitres et aux troisièmes mi-temps, tenues dans lancien mess des officiers de Fort Detrick, au cours desquelles il se contentait dun verre de vin quand tous les autres finissaient complètement ivres.
Ivins aimait avoir des bonbons sur son bureau et abreuvait de paroles quiconque osait sapprocher pour en prendre un. Quand il était énervé ce qui arrivait souvent il balbutiait et battait des bras pour se faire comprendre. Si vous receviez un mail avec un mauvais jeu de mots ou des bavardages, vous saviez qui blâmer. Il organisait une « messe hippie » dans léglise catholique St-Jean lEvangéliste de Frederick, jouant du clavier et de la guitare acoustique. Il était volontaire à la Croix-Rouge. Ses collègues le considéraient comme intelligent et généreux. « Il avait de lexpérience et était prêt à la partager » se rappelle Hank Heine, un ami dIvins et un collègue au sein de la très soudée division de bactériologie. « Le jour de mon arrivée, il ma dit de venir le voir si javais besoin daide. »
Il nest donc pas surprenant que, lorsque le FBI mit en place une petite équipe, après les premières attaques, destinée à le soutenir sur le plan scientifique, Ivins souhaita ardemment y participer. Peut-être un peu trop. Alors que dautres membres de lInstitut jurèrent quaucun deux ne pouvait être responsable de ces attaques, Ivins suggéra plusieurs noms de collègues, actuels ou anciens, comme des coupables potentiels. « Il est rare que quelquun pointe des collègues du doigt » dit Thomas Dellafera, lagent de linspection des postes qui participa à lenquête, « mais lui le fit. Ce type aurait écrasé sa propre mère. »
Ivins envoya régulièrement des mails à des amis et des connaissances à propos de lenquête, y compris à une ancienne coreligionnaire de luniversité de Caroline du Nord appelée Nancy L. Haigwood. Une photo quIvins envoya à Haigwood devenue elle aussi une microbiologiste était particulièrement dérangeante : elle montrait Ivins tenant à main nue une boîte de Pétri pleine danthrax. Haigwood était déjà très énervée contre Ivins : il avait fait montre dune fascination excessive envers elle et les rituels de sa sororité Kappa Kappa Gamma, et avait essayé dattirer son attention par tous les moyens possibles depuis lors. Par exemple, elle soupçonnait Ivins davoir peint les lettres grecques KKG en rouge sur la clôture de la maison de son ami, plusieurs années après la fin de leurs études. Lorsque la Société américaine de microbiologie demanda à ses membres daider à lenquête, Haigwood pensa à Ivins. « A ce moment précis, jai su que cétait lui » dit-elle. Elle fit part de son sentiment au FBI, qui envoya deux agents pour linterroger mais ne sembla pas intéressé par son intuition à ce moment-là.
Assis sur le capot de son SUV Toyota parqué au coin du tarmac de laéroport Pulliam de Flagstaff, Arizona, Paul Keim regardait les couleurs changeantes du ciel au crépuscule. Microbiologiste à luniversité du Nord Arizona, Keim est responsable de lune des plus grandes collections danthrax au monde, plus de 1000 échantillons. Cet après-midi-là, il avait reçu un appel du FBI lui demandant de réceptionner un nouveau spécimen : du liquide céphalo-rachidien provenant de la première victime, léditeur Robert Stevens. Vers 19 heures, un avion Gulfstream atterrit et sarrêta près de la voiture de Keim. Avant même larrêt des moteurs, une femme blonde descendit de lavion, traversa la piste et tendit à Keim une boîte. Il prit la boîte et la ramena directement à son laboratoire.
Keim était connu parmi ses collègues pour avoir développé un test ADN permettant didentifier la souche dun échantillon de Bacillus anthracis. En analysant certaines sections du génome de lanthrax, Keim pouvait identifier des séquences répétitives de nucléotides révélateurs de la souche. Dix heures après la réception du spécimen, Keim avait terminé son analyse de lanthrax qui avait tué Stevens. La signature pointait vers une souche particulièrement virulente connue sous le nom dAmes. Cette souche était utilisée principalement dans des laboratoires US pour tester des vaccins et autres traitements. En dautres termes, lattaque à lanthrax avait très certainement été lancée depuis le sol américain.
Les scientifiques
Lenquête sur les attaques à lanthrax de 2001 nécessita un travail scientifique sans précédent produit principalement par des chercheurs US. Quelques-uns des principaux acteurs :
Hank Heine
Un des plus proches amis dIvins à la division de bactériologie de lInstitut.
Paul Keim
Démontra que la souche danthrax utilisée dans les attaques était identique à celle utilisée dans de nombreux laboratoires US.
Pat Worsham
Identifia les quatre mutants présents dans lanthrax utilisé dans les attaques.
Claire Fraser-Liggett
Dirigea léquipe de généticiens chargée danalyser lADN de lanthrax.
Les échantillons des attaques suivantes provenaient également de la souche Ames. Ce fut la première percée significative des enquêteurs. En fait, ce fut leur unique percée : sous tout autre angle, le cas semblait insoluble.
Contrairement à une enquête normale pour meurtre, les victimes navaient presque rien en commun. Les lettres ne portaient aucune empreinte ou ADN humain. Le lieu de dépôt des envois était inconnu. Cétait suffisant pour rendre fou linspecteur des Postes Dellafera. Parce que les attaques utilisaient le système postal, Dellafera, qui dirigeait jusque là une unité de sept personnes soccupant du vol de courrier, fut nommé dans léquipe de pilotage de lenquête. Maintenant, ce natif du Connecticut interviewait des centaines demployés postaux pour voir sils avaient remarqué des enveloppes suspectes. Il fit chou blanc. Rapidement, il devint apparent quil ne sagissait pas seulement de trouver qui-lavait-fait, mais aussi où-lavait-t-il-fait, pourquoi-lavait-t-il-fait et comment-lavait-t-il-fait.
Le rapprochement de lanthrax des attaques de la souche Ames donnait un point de départ à lenquête, mais dans une certaine mesure seulement. Découvrir sa source nécessiterait un degré de précision bien plus élevé. Plus dune dizaine de laboratoires et des milliers de chercheurs utilisaient la souche Ames. En identifier un en particulier serait compliqué, tous les échantillons étant quasiment identiques génétiquement. Tous les échantillons en circulation provenaient dune génisse morte à Sarita, Texas, en 1981. En prenant une analogie balistique, Keim connaissait le calibre de larme utilisée, mais les balle tirées pouvaient lavoir été par un millier darmes différentes.
Pour espérer obtenir léquivalent de la signature mécanique dune arme pour cet anthrax, les scientifiques devaient aller au-delà des tests de Keim, qui se limitaient à huit zones du génome, avec quelques centaines de paires de bases chacune. Ils devraient décoder lensemble du génome, 5.2 millions de paires de bases. Donc ils se tournèrent vers Claire Fraser-Liggett.
Cheveux foncés, mâchoire carrée, les joues dun top-modèle, Fraser-Liggett fut lune des pionnières du séquençage du génome. En 1995, avec des collègues de lInstitut de recherche génomique, elle publia la séquence complète de lADN dune bactérie. J. Craig Venter, alors son époux, pilota leffort du secteur privé pour réussir le séquençage du génome humain à la fin des années 90. Au moment des attaques, elle et son équipe avaient déjà révélé le code génétique de dizaines de micro-organismes y compris la bactérie responsable de la maladie de Lime et de la syphilis. Et ils travaillaient déjà sur lanthrax un échantillon Ames de Porton Down, un laboratoire britannique de biodéfense.

Léquipe de Fraser-Liggett entrepris immédiatement le séquençage de lanthrax prélevé sur Robert Stevens. Lespoir était de trouver quelques séquences de nucléotides uniques qui suffiraient à identifier la source. En 2001, le séquençage génétique était encore si difficile et coûteux quil faudrait des mois pour le réaliser.
Pendant ce temps, les attaquent continuaient. Le 28 octobre, Kathy Nguyen une employée à léconomat dun hôpital âgée de 61 ans tomba malade de manière si subite quelle pouvait à peine parler à son entrée aux urgences. Elle mourut trois jours plus tard, peu après que lanthrax ait été diagnostiqué. Personne narrivait à déterminer comment elle avait été infectée. Une lettre à lanthrax avait peut-être été frottée contre un colis pour lhôpital en route et avait laissé de spores. Puis, deux semaine plus tard, une lettre adressée au sénateur Patrick Leahy fut trouvée dans une pile de courrier en quarantaine.
Le même jour, Ottilie Lundgren, une veuve de 94 ans, entrait à lhôpital pour une toux légère et un affaiblissement. Rien de grave, mais les médecins décidèrent de la garder en observation pour la nuit. Elle vivait dans la petite bourgade rurale dOxford, Connecticut, et ne voyait presque personne. Quatre jours plus tard, les médecins confirmèrent linfection à lanthrax. Le lendemain, elle décédait.
Le Centre de contrôle et de prévention des maladies (CDC) avertit que « des dizaines de milliers de lettres, et peut-être plus, [pouvaient être] à un certain degré potentiellement dangereuses dû à une contamination par contact. » Le pays, toujours sous le choc du 11 septembre, fut plongé dans un état de panique encore plus profond. Chaque salle de rédaction de New York et chaque bureau de Washington devint un laboratoire de biosécurité de fortune. Les gens prenaient dassaut les cabinets médicaux pour obtenir du ciprofloxacin, le puissant antibiotique utilisé pour contrer lanthrax ; certains allèrent au Canada lorsque les pharmacies US furent en rupture de stock. Et les canulars commencèrent. Un extrémiste anti-avortement envoya 554 lettres contenant une poudre à des cliniques pratiquant lIVG dans tout le pays. Le 4 décembre, Tom Ridge, le chef de la sécurité intérieure nouvellement nommé, déclara quil mettait la population « en état dalerte générale ».
Le directeur du FBI, Robert Mueller, tint des séances quotidiennes et parfois deux fois par jour sur cette enquête, demandant des rapports détape à tout instant. « Qui serait assez courageux pour venir lui dire quil ny avait rien de nouveau » se rappelle un vétéran du FBI. Mais ils navaient pas presque rien.
Pat Worsham, une de collègues dIvins, ressentait laccélération des événements « comme si le monde était devenu fou ». Une spécialiste de lanthrax, amatrice de lecture, à lallure composée de bibliothécaire. Elle était habituée au train-train de lInstitut. Maintenant elle était au centre dune enquête nationale frénétique sur le bioterrorisme.
Worsham avait acquis ses galons dans la communauté scientifique en étudiant les variantes danthracis, travail au cur de la recherche dun vaccin. Il était donc logique que Terry Abshire, une technicienne de lInstitut, lui ait envoyé la photo dune boîte de Pétri contenant des colonies danthracis à lapparence étrange. Abshire laissa incuber des colonies de spores, provenant de la lettre adressée à Leahy, deux à trois jours de plus quil nétait usuel de le faire dans un tel cas. Lorsquelle sortit les colonies de lincubateur, elle remarqua que de nombreuses colonies avaient une coloration jaunâtre plutôt que le gris clair usuel. De plus, ces colonies semblaient avoir affecté le sang de chèvre servant de substrat, le tournant en un vert maladif.
Worsham étudia la photo, mais nétait pas sûre de ce que cela signifiait. Elle incuba donc un second échantillon provenant de la lettre adressée à Leahy et des colonies jaunâtres à lapparence étrange apparurent. Finalement, quatre variantes prédominantes furent identifiées. Deux présentaient deux cercles presque parfaitement concentriques. La troisième était un peu plus petite et plus irrégulière. La quatrième était largement translucide. Worsham, par la suite, incuba des colonies à partir des spores trouvées sur les lettres adressées à Daschle et au New York Post. Les mêmes colonies mutantes apparurent.
Worsham, dune nature prudente, nen tira pas de conclusion hâtive. « Bon, dit-elle à des collègues, elles semblent similaires, mais ne ont peut-être pas similaires ». Mais elle soupçonnait quelles étaient spécifiques aux attaques à lanthrax, ce qui pourrait donner aux enquêteurs une caractéristique à rechercher.
Pendant ce temps, le FBI utilisa une méthode denquête plus conventionnelle : le profilage comportemental. Il analysa les lettres avec une précision talmudique, recherchant tout ce qui pouvait paraître inhabituel. Lévocation du 11 septembre « 09-11-01 » correspondait à lhabitude américaine de placer le mois avant le jour. La mention de « Allah est grand » à la fin de la lettre ne paraissait pas authentique ; un musulman dévot aurait commencé la lettre par ces mots et utilisé lexpression « Allahu akbar ». Les profileurs en conclurent que lexpéditeur était probablement un fanatique de la spore du type Unabomber un solitaire très bien formé, vraisemblablement au sein de la communauté de biodéfense US. En public, il éviterait le conflit, prévinrent-ils. Il préférerait plutôt harasser des gens anonymement. Ni les destinataires des lettres, ni les boîtes aux lettres utilisées navaient été choisies au hasard. Les lettres portant le tampon postal de Trenton, les profileurs suggérèrent que lexpéditeur habitait ou travaillait à proximité.
Les enquêteurs dressèrent une liste des 621 boîtes aux lettres qui aboutissaient au centre de tri postal de Trenton. Ils commencèrent par les boîtes les plus isolées, se disant quun résident choisirait un emplacement où il aurait le moins de chance dêtre vu. De nuit, léquipe testa une boîte après lautre, à la recherche de résidus danthrax. Une boîte après lautre, le test fut négatif.
Par ailleurs, les agents du FBI demandèrent aux spécialistes de biodéfense sils pouvaient suggérer quelquun comme un suspect potentiel. Un nom fut mentionné régulièrement : Steven Hatfill, un médecin ayant travaillé à lInstitut en virologie. Hatfill connaissait lanthrax ; il avait fait sa médecine et son internat en Afrique du Sud, où il avait observé des patients présentant des infections cutanées causées par lanthrax. Il avait réalisé chez SAIC une entreprise travaillant pour les militaires une présentation concernant une attaque bioterroriste. Le scénario retenu : lenvoi anonyme denveloppes remplies danthrax. Dans les mois ayant précédé les attaques, il avait commandé du ciprofloxacin.
Mais, ce qui le faisait ressortir du lot, cest quil était un fana de sport parmi des intellos, ayant pratiqué la lutte à luniversité et été soldat. Alors que ses collègues ne publiaient que dans des revues comme Le journal des maladies infectieuses, Hatfill écrivait dans le journal conservateur Insight, prétendant cuisiner des cocktails infectieux dans sa cuisine, de manière à dramatiser la menace des agents pathogènes produits à la maison. Parmi les milliers demployés présents et passés en biodéfense, Hatfill devint le centre de lattention du FBI.
Ivins, pendant ce temps, devint un allié respecté des enquêteurs, les promenant à travers les détails du cycle de vie de lanthrax. Le 22 janvier 2002, il dessina un diagramme qui illustrait pourquoi des mutants apparaissaient dans les spores et pourquoi cétait important.
Lanthrax nest pas une bactérie comme les autres. A létat de spore, anthracis peut survivre en léthargie pendant des décennies, peut-être même des siècles. Lorsquelle pénètre dans un animal, elle sactive et commence à se reproduire. Comme tout être vivant, anthracis génère des mutants lorsquil se multiplie. Mais ces mutants ont de la peine à entrer en léthargie. Lorsque lanthrax perd son hôte, beaucoup de mutants meurent et la bactérie revient presque à un état quasiment pur. Cest comme si les lois de lévolution ne sappliquaient pas.
Le traitement de lanthrax par la communauté scientifique inhibait encore plus le processus de mutation. Ivins, par exemple, conservait des lots danthracis qui étaient purs, virulents, « à deux doigts », comme il le dit, de la souche originelle de la génisse Ames. Ivins sélectionnait alors les colonies paraissant les plus saines pour les transmettre aux autres chercheurs. Autrement dit, les chercheurs utilisant les spores dIvins limitaient la possibilité de mutation. Ils revenaient encore et toujours à létat de 1981.

Lanthracis trouvé dans les lettres était totalement différent de sa souche, expliqua Ivins aux enquêteurs. Worsham avait démontré que lanthrax des attaques produisait de multiples mutants quand il était incubé. Cela impliquait que ces spores étaient le résultat de multiples générations de culture, contrairement à la souche de la génisse ; les colonies atypiques ne pouvaient provenir que de répétitions du cycle évolutionnaire. « Daschle ≠ cultures de B.I. » écrivit Ivins sur le diagramme, utilisant ses propres initiales. Les agents prirent note de son analyse, qui semblait parfaitement logique même si un peu confuse à ce moment-là. Ils notèrent également sa suggestion dessayer de différencier son anthrax de celui présent dans les lettres au moyen dune analyse génétique.
Bien sûr, pour que la génétique puisse être utile, le FBI devrait collecter un ensemble représentatif déchantillons danthracis pour servir de base à la comparaison. Cest ce quil décida de faire. Il établit un entrepôt déchantillons sous clef dans le laboratoire de Keim et un autre à lInstitut. Des scientifiques du monde entier furent priés denvoyer un échantillon de tous les lots Ames en leur possession. Ivins et Worsham, entre autres, participèrent à lélaboration des directives appropriées.
Les directives contenaient une demande de ne pas se limiter aux colonies saines une pratique standard dans ce domaine. Les scientifiques devaient prendre un échantillon représentatif de chaque lot et inclure les mutants. Ivins finit de livrer ses échantillons en avril 2002.
Parmi les échantillons dIvins, il sen trouvait un particulièrement virulent un mix quil développa en 1997. Il sagissait de 164 litres danthrax résultant de 35 étapes différentes de production, réduits à un litre presque pur. Le flacon était marqué RMR-1029.
Le même mois, Ivins fit quelque chose qui surprit tout le monde. Pour une raison quelconque, il commença à tester son bureau et ses laboratoires de confinement, à la recherche de spores. Cétait une violation majeure du protocole de lInstitut. Des équipes spécialement entraînées sont chargées de gérer les éventuelles contaminations.
Le 18 avril, Ivins dit à ses collègues de la division de bactériologie ce quil avait fait. Ils prirent peur. Laction dIvins était non seulement dangereuse, mais pouvait aussi être perçue comme une tentative de cacher des preuves. « Bruce, lui dit son collègue et ami Jeff Adamovicz, tu ne comprends pas limpression que cela donne de toi ».
Le lendemain, lInstitut tint une assemblée générale pour discuter des actions dIvins et entreprendre une chasse systématique à la spore. « On minterdit maintenant de jouer au "cowboy", écrira-t-il ultérieurement à un ami dans un mail ; je ne peux plus penser ou agir par moi-même sans que ma hiérarchie minterroge à ce sujet. Je suis sûr que cest une punition. »
Le FBI décida dinterroger Ivins. Ils avaient de nombreux points à aborder. Ils avaient découvert quIvins aimait passer un nombre inhabituel dheures dans ses laboratoires de bioconfinement, situés dans les entrailles bétonnées et sans fenêtre de lInstitut. Pourquoi vous enfermez-vous aussi longtemps là-dedans ? « Je ne pense pas que quiconque imagine à quel point cest calme et silencieux en dehors des heures de travail, écrivit-il à un ami après linterrogatoire ; en soirée, [la zone] B3 pourrait aussi bien être sur Mars. »
Malgré tout, lattention du FBI était toujours fixée ailleurs. Les enquêteurs avaient décortiqué le passé de Steven Hatfill et trouvé des incohérences. Par exemple, il prétendait avoir obtenu un doctorat ; en fait, il ne la jamais reçu. Sil mentait à ce sujet, il pouvait bien garder dautres secrets.
En juin 2002, des agents demandèrent à Hatfill de pouvoir rechercher de lanthrax dans son appartement. A leur arrivée sur place, il y avait des caméras de télévision partout. Les chaînes dinformation traitaient laffaire en direct. Même si la recherche ne donna aucun résultat, John Ashcroft le ministre de la justice déclara le 6 août durant lémission Today que Hatfill était une « personne intéressante » pour lenquête.
Deux jours plus tard, après avoir testé plus de 600 boîtes aux lettres de la région centrale du New Jersey, les enquêteurs en trouvèrent finalement une à Princeton contenant des spores. Contrairement aux indications des profileurs, elle se trouvait à un carrefour animé à langle nord-ouest de luniversité de Princeton, avec du trafic à toute heure du jour et de la nuit. Des agents montrèrent la photo dHatfill à tout le voisinage, mais personne ne le reconnut.
Partie 2 de larticle à suivre prochainement
En lien avec larticle :
Les réactions les plus appréciées
 Spécial !
Spécial !


 Prépa Bouquin
Prépa Bouquin



 visiteurs
visiteurs visiteurs en ligne
visiteurs en ligne 1 membre
1 membre



 S
S

Complot intérieur
Complot intérieur
 Haut
Haut 

